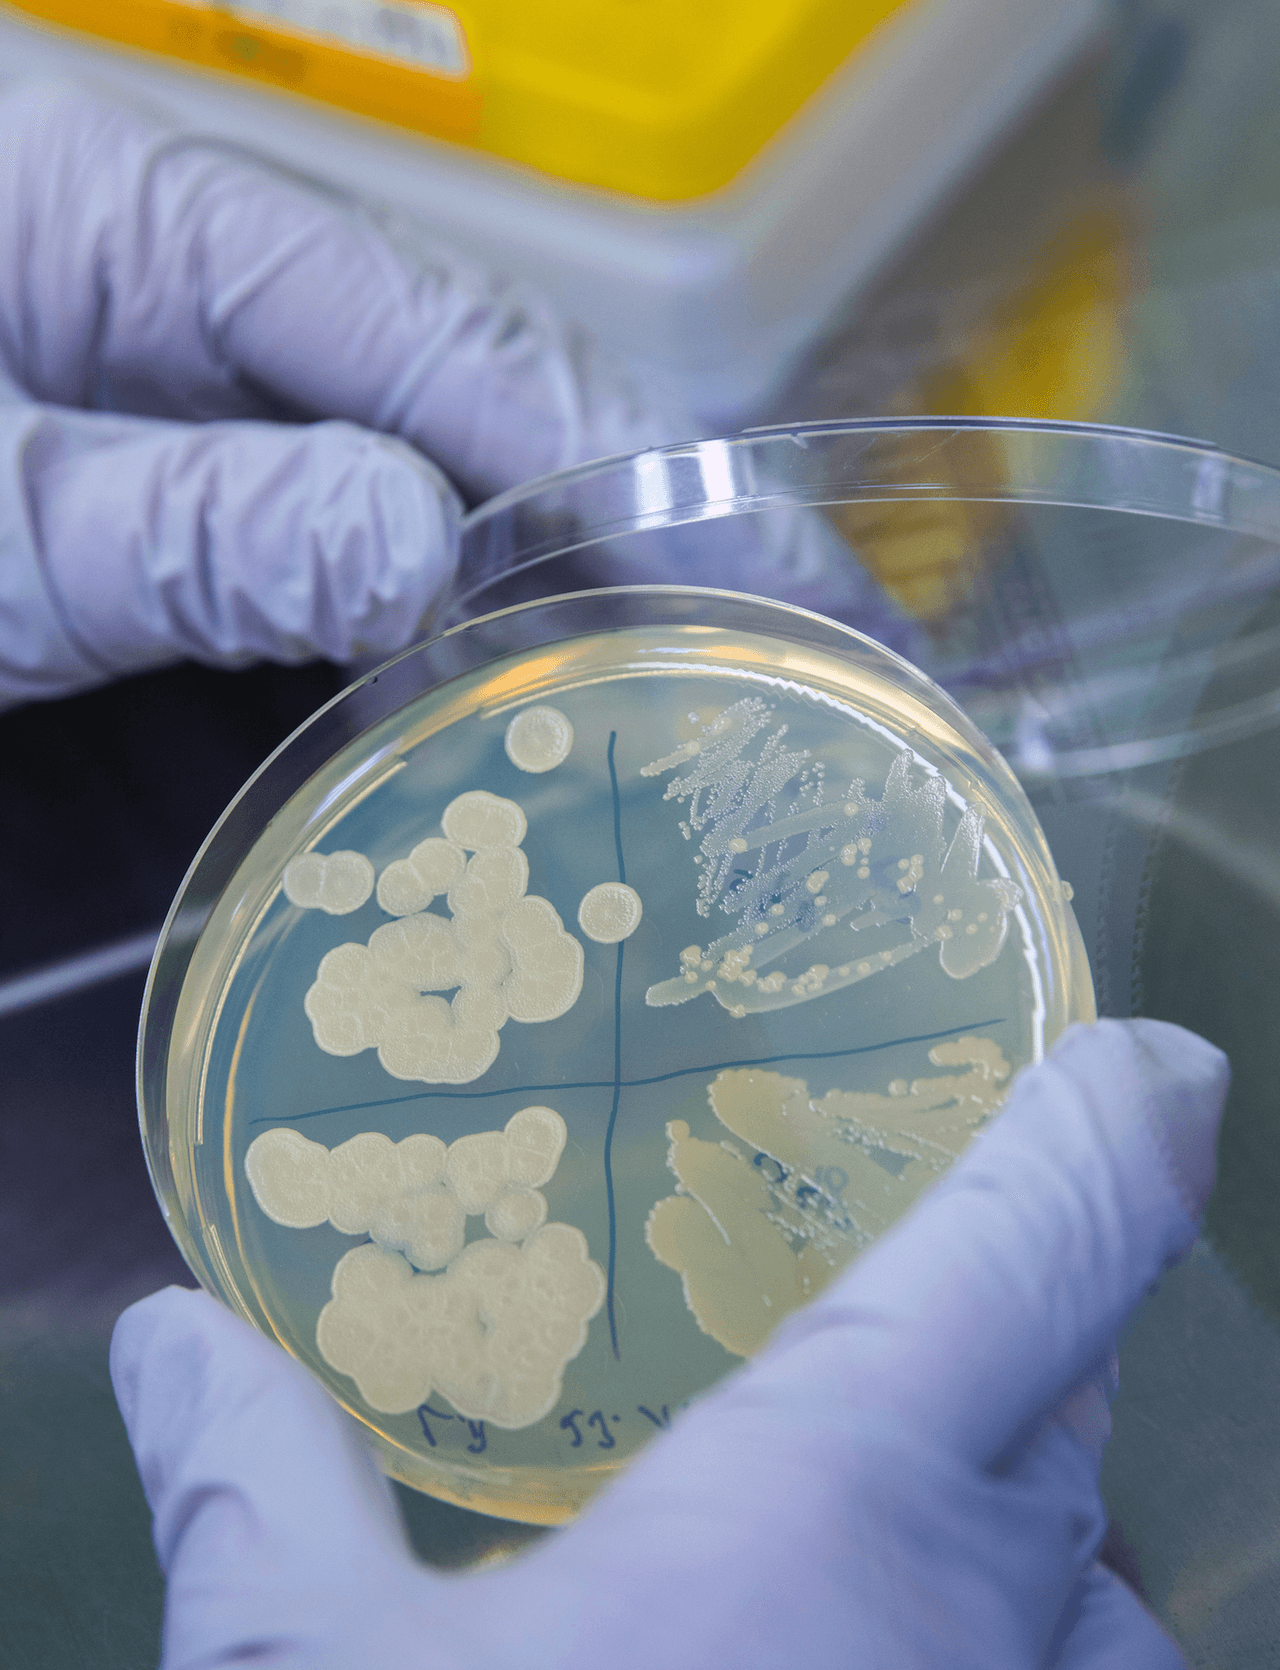
El brote de E. coli se extiende a Illinois, y a otros nueve estados

Una jueza condena a Adel Daoud a 16 años de prisión en caso de terrorismo en Chicago
Daoud tenía 18 años cuando fue arrestado después de estacionar un vehículo fuera de en bar porque presionió ese botón. Los agentes del FBI suministraron el dispositivo falso y lo hicieron oler a diesel para convencer a Daoud de que era real.
LO MÁS RECIENTE
Asciende a tres el número de muertos después de la explosión de la fábrica de Waukegan
Tres personas están muertas y una más sigue desaparecida luego de una gran explosión en una planta de silicona en Waukegan el viernes por la noche.
Porque 'blackface' es ofensivo: Esto fue lo que pasó en la secundaria Homewood-Flossmoor
Hace casi una semana surgieron imágenes de estudiantes de la secundaria Homewood-Flossmoor con pintura cafe en la cara, haciendo burla a las niñas afroamericanas. Para entender por qué el blackface provocó una reacción de rechazo tan profunda, hay que entender de dónde proviene.
¿Cuales son los últimos 4 dígitos de su código postal? El Servicio Postal de EEUU dice que debe usarlos
El Servicio Postal de Los Estados Unidos (USPS) mando cartas a domicilios pidiéndole a residentes que por favor usen los últimos 4 dígitos de su código postal además de los 5 dígitos que la mayoría de la gente ya se sabe. USPS dijo que esto ayudará a que ellos tengan la información correcta y podrán entregar su correo con más rapidez.

Miles de scooters llegan a Chicago este verano como una opción de transporte público
La ciudad de Chicago anunció el jueves que pondrá a prueba más de 2,500 scooters este 15 de julio.
Orden de registro detalla cómo la policía encontró el cuerpo de AJ Freund
Esos detalles trágicos surgieron en una declaración del detective Edwin Maldonado del condado de McHenry en una solicitud de orden de registro el 24 de abril.

Trabajadores en los Colegios Comunitarios de Chicago inician huelga por falta de contrato y bajos salarios
Trabajadores del sindicato local 1708 dicen que no han llegado a un acuerdo respecto a sus contratos, que están inconformes con el salario que reciben y que incluso muchos de ellos tienen un sueldo por debajo del mínimo establecido en la ciudad.